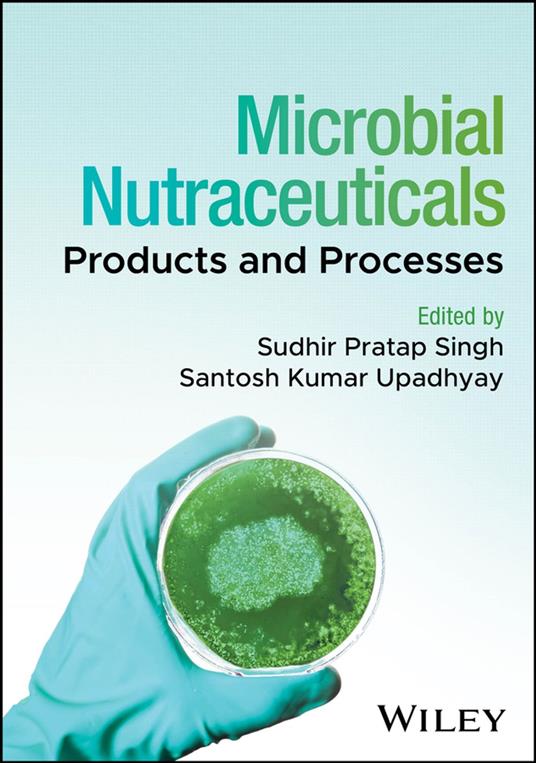

L’articolo è stato aggiunto alla lista dei desideri
IBS.it, l'altro eCommerce
Microbial Nutraceuticals
Cliccando su “Conferma” dichiari che il contenuto da te inserito è conforme alle Condizioni Generali d’Uso del Sito ed alle Linee Guida sui Contenuti Vietati. Puoi rileggere e modificare e successivamente confermare il tuo contenuto. Tra poche ore lo troverai online (in caso contrario verifica la conformità del contenuto alle policy del Sito).
Grazie per la tua recensione!
Tra poche ore la vedrai online (in caso contrario verifica la conformità del testo alle nostre linee guida). Dopo la pubblicazione per te +4 punti
Altre offerte vendute e spedite dai nostri venditori



Tutti i formati ed edizioni
Promo attive (0)
An exploration of the latest advances in the application of microbial nutraceuticals in healthcare, food production, and agriculture In Microbial Nutraceuticals: Products and Processes, a team of distinguished researchers delivers an up-to-date and authoritative discussion of the recent advances in the application of microbial nutraceuticals and their implementation in the health, food, and agriculture sectors. The book begins with an overview of microbial nutraceuticals before moving on to discussions of more specific topics, including microbial cell factories for the production of essential amino acids, microbial production of dietary short-chain fatty acids, and microbial sources for bioactive peptides conferring health benefits. Readers will also find: A thorough introduction to symbiotic products with nutraceutical impact Comprehensive explorations of postbiotic supplements with nutraceutical significance Practical discussions of microbial production of carotenoids Complete treatments of microbial engineering for multivitamin production This book is intended for academics, scientists, and researchers working in the field of microbial nutraceuticals. Additionally, it will benefit professionals working in the agri-biotech industries, as well as graduate and post-graduate students with an interest in the subject.
L'articolo è stato aggiunto al carrello
Formato:
Gli eBook venduti da IBS.it sono in formato ePub e possono essere protetti da Adobe DRM. In caso di download di un file protetto da DRM si otterrà un file in formato .acs, (Adobe Content Server Message), che dovrà essere aperto tramite Adobe Digital Editions e autorizzato tramite un account Adobe, prima di poter essere letto su pc o trasferito su dispositivi compatibili.
Cloud:
Gli eBook venduti da IBS.it sono sincronizzati automaticamente su tutti i client di lettura Kobo successivamente all’acquisto. Grazie al Cloud Kobo i progressi di lettura, le note, le evidenziazioni vengono salvati e sincronizzati automaticamente su tutti i dispositivi e le APP di lettura Kobo utilizzati per la lettura.
Clicca qui per sapere come scaricare gli ebook utilizzando un pc con sistema operativo Windows
L’articolo è stato aggiunto alla lista dei desideri